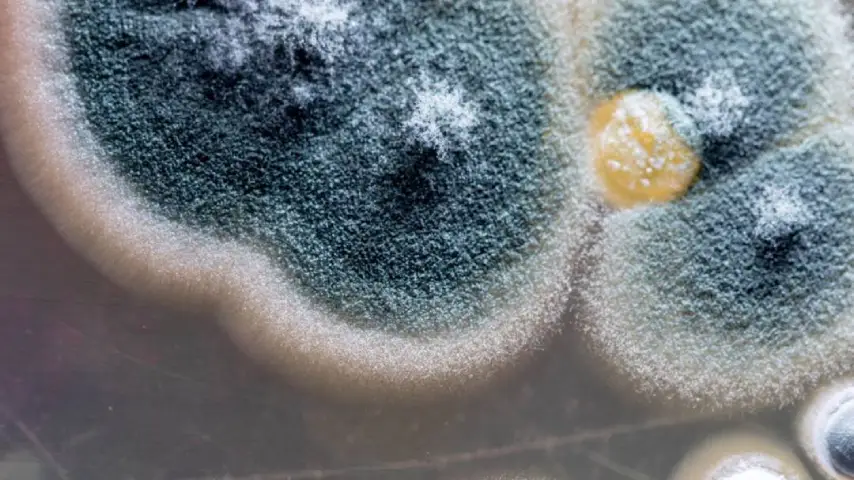

Get A Free Quote!
Competitive Rates
We offer top-quality dryer vent cleaning in Chicago with fast, reliable service and competitive rates that fit your budget.
Excellent Service
We thoroughly clean and ensure every vent is meticulously cleared of lint and debris to maximize safety, and efficiency.
Mon-Fri 9am-5pm
We’re available Monday through Friday from 9 AM to 5 PM, providing convenient, reliable dryer vent cleaning and repair.
Large Service Area
We proudly serve a large area across Chicago and the surrounding suburbs, bringing reliable, expert dryer vent cleaning.
Reach Out To Get Scheduled Today!

Residential Dryer Vent Cleaning
Dryer Vent Type: Residential
Professional Cleaning
More Details
Residential dryer vent cleaning involves removing lint, dust, and debris from the dryer vent system to improve airflow and reduce fire risk. The process typically includes cleaning the lint trap, vent duct, and exterior vent cover using specialized tools. This helps the dryer run more efficiently and safely.

Commercial Dryer Vent Cleaning
Dryer Vent Type: Commercial
Professional Cleaning
More Details
Commercial dryer vent cleaning involves clearing lint and debris from larger, more complex vent systems typically found in multi-unit buildings or businesses. It includes cleaning multiple vents, ducts, and exhaust points using industrial-grade tools to ensure safety, efficiency, and compliance with fire codes.

Dryer Vent Repair
Professional Vent Repair
Satisfaction Guaranteed
More Details
Dryer vent repair involves fixing damaged, disconnected, or improperly installed vent systems to restore safe and efficient airflow. This may include replacing crushed or outdated ducts, sealing leaks, securing loose connections, and ensuring the system meets current safety codes.

Dryer Vent Replacement
Professional Replacement
Satisfaction Guaranteed
More Details
Dryer vent replacement involves removing old, damaged, or non-code-compliant vent systems and installing new, properly sized and safe ductwork. This ensures optimal airflow, reduces fire risk, and helps the dryer operate efficiently. High-quality materials are used to meet safety standards and long-term performance.

Duct Booster Fan Install
Unlock Your Dryers Full Potential
Professional Installation
More Details
A dryer vent duct booster fan installation involves adding a fan to long or complex dryer vent systems to improve airflow and prevent lint buildup. It helps the dryer exhaust air more efficiently. Proper installation ensures the fan activates automatically and maintains safe, effective dryer operation.

Termination Replacement
Vehicle Type: Van
4 Doors, 8 Seats
More Details
What’s In Your Dryer Duct?

TOYS

FOOD

PESTS

JUNK
Why Clean Your Dryer Ducts?
ALLERGENS
Cleaning your dryer vents helps prevent allergens by reducing lint, dust, and moisture buildup that can circulate through your home.

AIRFLOW
Cleaning your dryer vents improves airflow, helping your dryer run more efficiently and reducing overall drying times.

DRYER FIRE
Routine cleanings of dryer vents removes lint buildup, reducing the risk of overheating and preventing dreaded dangerous dryer fires.

LIFESPAN
Cleaning your dryer vents reduces strain on your dryer, helping it run more smoothly and efficiently while extending the units lifespan.
Scheduling Has Never Been Easier!
Reserve by Text
Text us 24/7
Reserve by Phone
Call Us 24/7
Reserve Online
In Just a Few Clicks
